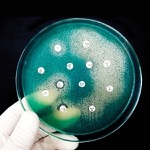

Video edited by Meaghan Lee Callaghan; Hosted by Marie Rosenthal, MS
Jonathan Stokes, PhD, a microbiologist and an assistant professor of biochemistry and biomedical sciences at McMaster University, in Hamilton, Ontario, talks with managing editor Marie Rosenthal, MS, about how artificial intelligence, specifically a subtype called machine learning, is adding to antibiotic discovery.
Learn more from Dr. Stokes in our July/August 2025 cover story, and stay tuned for part 2 featuring more from their conversation.